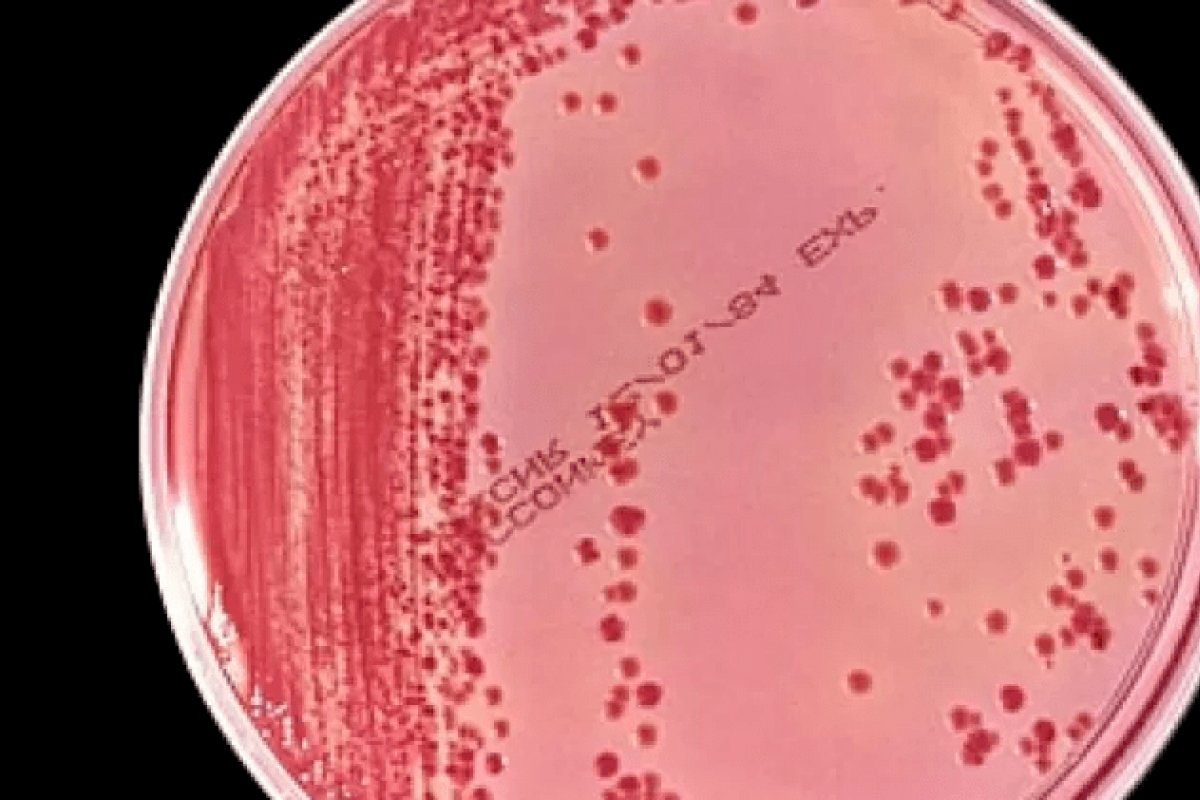
Brasil usa poucos testes para detecção do coronavírus

Brasil usa poucos testes para detecção do coronavírus
Aparecimento de novas cepas podem trazer uma terceira onda para o país
Foto: Reprodução
Mesmo com o aparecimento de novas cepas do coronavírus e do risco do Brasil entrar na terceira onda de contaminações, comparado com outros países do mundo, poucos testes foram aplicados entre a população brasileira.
Segundo um levantamento realizado pela Info Tracker, desde o início da crise sanitária, estados e municípios aplicaram 49,4 milhões de testes. Os dados foram coletados da plataforma internacional Worldômetros, que compila as informações a partir dos testes informados pelos estados, independentemente de quem entregou o exame.
Além de indicar que a pandemia está fora de controle no Brasil, os poucos testes comprometem a descoberta de novas variantes do coronavírus. Além disso, também compromete identificar se o vírus passa a infectar mais ou é mais virulento, considerando o aparecimento de uma nova variante.
É o caso do P1, originado em Manaus e rebatizado de gama pela OMS . Descoberta em janeiro, a cepa já contamina nove em cada dez brasileiros.
De acordo com relatório dos fiscais do TCU, ainda a ser votado, sobre o desempenho do Ministério da Saúde em relação à crise sanitária, o Reino Unido sequenciou em uma semana quase o dobro do que o Brasil sequenciou em um ano de pandemia.
No documento, o Reino Unido analisa semanalmente 9.900, algo em torno de 6% a 8% dos casos positivos. Já a Dinamarca, "outro país líder em vigilância genômica", sequencia aproximadamente 12% dos casos positivos.
De acordo com o Ministério da Saúde, o sequenciamento genômico é realizado por diversos laboratórios do país e, por isso, "muitos resultados podem ter sido notificados apenas aos municípios ou estados ou, até mesmo, ainda não foram notificados a nenhum ente do SUS".


